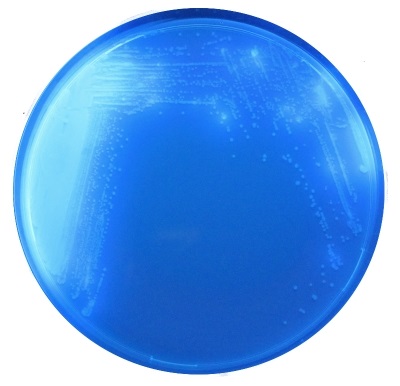

Produkto kodas: CD122
Tiekėjas: CHROMagar
Paketo dydis: 5000 ml
Uusi käänteentekevä fluorogeeninen elatusaine CHROMagar™ C. difficile yksinkertaistaa ja nopeuttaa C. difficilen viljelyä.
1. Nopeampi tunnistus perinteisiin alustoihin verrattuna
Suuret, noin 2 miilimetrin kokoiset C. difficile -pesäkkeet ovat tunnistettavissa jo 24 tunnin
inkuboinnin jälkeen, kun perinteiset alustat vaativat 48 tuntia.
2. Suuri herkkyys ja spesifisyys
C. difficile muodostaa fluoresoivia pesäkkeitä, jotka todetaan UV-valossa (365 nm).
Näytteen muu bakteerikasvu estyy lähes täysin.
3. Joustavuus
CHROMagar™ C. difficile sopii sekä kliinisille että ympäristönäytteille.
CHROMagar™ C. difficile –maljoja inkuboidaan anaerobisesti 24 tuntia +37°C:ssa.